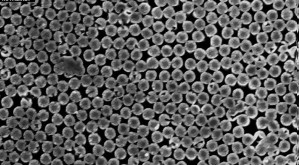

Ново наноустройство генерира електроенергия от изпаряваща се вода и слънчева светлина
Изследователи от Лабораторията по нанонаука за енергийни технологии (LNET) към Федералния политехнически университет в Лозана (EPFL) в Швейцария разработиха устройство, което непрекъснато генерира електроенергия от изпаряваща се вода, като използва топлина и слънчева светлина. Системата работи с обикновена чешмяна или морска вода, но не функционира с високопречистена вода. Технологията представлява наноразмерно хидроелектрическо устройство, което извлича […]
Прочети цялата публикация




 Революционен слънчев панел генерира енергия както от слънчева светлина, така и от дъжд
Революционен слънчев панел генерира енергия както от слънчева светлина, така и от дъжд  Ядрената програма на Иран: рентабилна ли е
Ядрената програма на Иран: рентабилна ли е  Какво задължително се прави на втория ден от Великден - Мокрия понеделник
Какво задължително се прави на втория ден от Великден - Мокрия понеделник  Ергенът Стоян най-накрая с първа целувка преди да изчезне в следващия епизод (ВИДЕО)
Ергенът Стоян най-накрая с първа целувка преди да изчезне в следващия епизод (ВИДЕО)  Енергийният локдаун за напреднали
Енергийният локдаун за напреднали  Антарктида се топи отдолу: Учени предупреждават за нова заплаха за ледените шелфове
Антарктида се топи отдолу: Учени предупреждават за нова заплаха за ледените шелфове  Задължително чипиране на кучета и котки се въвежда в Европа
Задължително чипиране на кучета и котки се въвежда в Европа  Земята има рядко предимство: Защо повечето обитаеми планети може да са мъртви
Земята има рядко предимство: Защо повечето обитаеми планети може да са мъртви  Новият собственик на Левски: Искам чрез клуба да върнем българския футбол на световно ниво
Новият собственик на Левски: Искам чрез клуба да върнем българския футбол на световно ниво  Ядрената енергетика е на пътя на своето възраждане 40 години след аварията в Чернобил, сочи анализ на АП
Ядрената енергетика е на пътя на своето възраждане 40 години след аварията в Чернобил, сочи анализ на АП  Ново наноустройство генерира електроенергия от изпаряваща се вода и слънчева светлина
Ново наноустройство генерира електроенергия от изпаряваща се вода и слънчева светлина  Говори Москва: Русия е готова за споразумение, но Киев няма право да диктува условия
Говори Москва: Русия е готова за споразумение, но Киев няма право да диктува условия  Бизнесът одобри варианта за депозитна система на служебния кабинет
Бизнесът одобри варианта за депозитна система на служебния кабинет  Лора Дърн заема мястото на Хелена Бонъм Картър в "Белият лотос 4"
Лора Дърн заема мястото на Хелена Бонъм Картър в "Белият лотос 4"  БАБХ иззе яйца и пилешко месо без документи на ГКПП „Капитан Андреево“
БАБХ иззе яйца и пилешко месо без документи на ГКПП „Капитан Андреево“  Двама напускат Реал Мадрид през лятото
Двама напускат Реал Мадрид през лятото  ФИФА по примера на БФС: Новото правило, което може да промени футбола
ФИФА по примера на БФС: Новото правило, което може да промени футбола  Очаквайте НА ЖИВО: Григор Димитров стартира в Екс ан Прованс
Очаквайте НА ЖИВО: Григор Димитров стартира в Екс ан Прованс  Кабинетът реши част от документите за разрешително за оръжие да се набавят служебно
Кабинетът реши част от документите за разрешително за оръжие да се набавят служебно